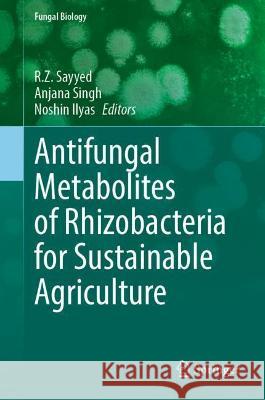

Książki: » Biologia i przyroda » Antifungal Metabolites of Rhizobacteria for Sustainable Agriculture
topmenu
 | Antifungal Metabolites of Rhizobacteria for Sustainable Agriculture
cena:605.23 zł |
| Antifungal Metabolites of Rhizobacteria for Sustainable Agriculture
cena:605.23 zł |